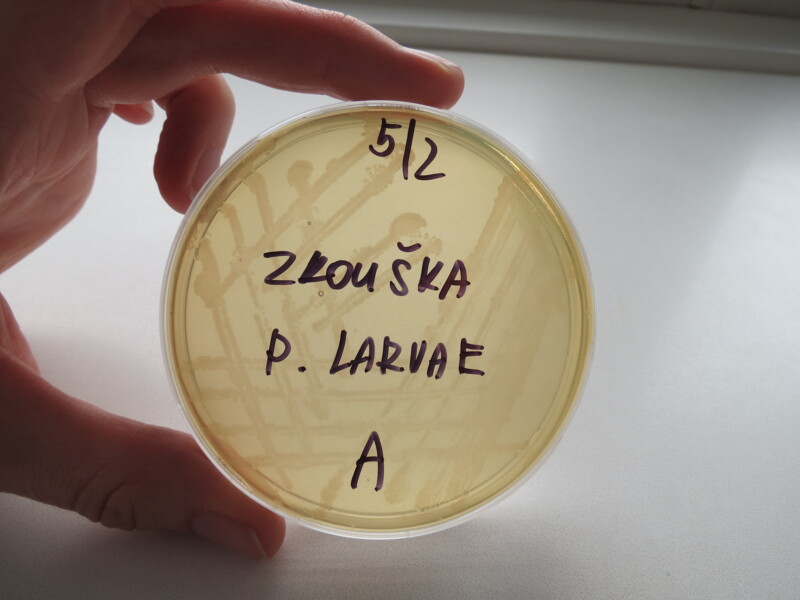

Moderní včelař 4/2026

E-shop PSNV
Možnost zakoupit toto číslo.
Toto číslo již nelze na e-shopu PSNV zakoupit.Editorial

František Weyda
206/4/4
Milé čtenářky, milí čtenáři, tématem tohoto dubnového vydání jsou laboratoře.
Světový den laboratorních zvířat

Marie Šotolová
206/4/4
Světový den laboratorních zvířat (World Day for Laboratory Animals; https://worlddayforlaboratoryanimals.org) spolu s Týdnem laboratorních zvířat je vždy 24. dubna od roku 1979 katalyzátorem hnutí za konec utrpení zvířat v laboratořích a zavedení pokročilých vědeckých technik bez použití zvířat.
Kalendárium

Slovo úvodem k tématu Laboratorní služby chovatelům včel

AGRO-LA, laboratoř se zaměřením na životní prostředí a zemědělství
Marie Šotolová, Petr Texl
206/4/7
Řeknete-li dnes AGRO-LA, mnoha lidem se vybaví jogurt. Další činností této společnosti jsou laboratorní analýzy pro životní prostředí a zemědělství, kam spadá i včelařství.
Celý článek je v tištěné a elektronické verzi Moderního včelaře.
Toto číslo Moderního včelaře si můžete zakoupit
Přehled pracovišť s nabídkou laboratorních vyšetření nemocí včel
- redakce
206/4/10
Tabulka laboratoří, poskytující komerční vyšetření na včelí patogeny a škůdce.
Celý článek je v tištěné a elektronické verzi Moderního včelaře.
Toto číslo Moderního včelaře si můžete zakoupit
Kontrolní laboratoře pro obchodovaný med

206/4/10
Na posledním semináři Asociace profesionálních včelařů představila Mgr. Pavla Kundríková laboratorní metody kontrol jakosti medu Státní zemědělskou a potravinářskou inspekcí.
Celý článek je v tištěné a elektronické verzi Moderního včelaře.
Toto číslo Moderního včelaře si můžete zakoupit
Laboratoř včelí biologie

Petr Texl, Marie Šotolová
206/4/12
Jediná laboratoř na akademické půdě v České republice nese název Laboratoř včelí biologie. Spadá pod katedru molekulární biologie a genetiky Přírodovědecké fakulty Jihočeské univerzity. S její vedoucí RNDr. Alenou Krejčí, Ph.D., jsme hovořili o výzkumech, na nichž se zde dělá.
Celý článek je v tištěné a elektronické verzi Moderního včelaře.
Toto číslo Moderního včelaře si můžete zakoupit
Princip separátoru objasněn

Petr Texl
206/4/14
Med vytékající z medometu obsahuje mnoho voskových částic, které vznikají při odvíčkování medných plástů. Včelaři zpravidla tento med filtrují přes různě propustná síta a dále ho nechávají vyčeřit.
Celý článek je v tištěné a elektronické verzi Moderního včelaře.
Toto číslo Moderního včelaře si můžete zakoupit
Když jeden teploměr nestačí

Karel Řehák
206/4/16
Senzor pro měření teploty v úlu je dnes běžným doplňkem úlových vah a včelaři poskytuje především informace o probíhajícím plodování.
Celý článek je v tištěné a elektronické verzi Moderního včelaře.
Toto číslo Moderního včelaře si můžete zakoupit
Trendy ve včelařském oblečení

Marie Šotolová
206/4/18
Poslední Apimondie nabízela několik stánků se včelařskými obleky. Jejich společným znakem byl důraz na barvy.
Celý článek je v tištěné a elektronické verzi Moderního včelaře.
Toto číslo Moderního včelaře si můžete zakoupit
Senzily a smysly včely medonosné

František Weyda
206/4/19
Včely mají bohaté smyslové vnímání. Prostřednictvím receptorů vnímají různé podněty hlavně z vnějšího, některé i z vnitřního, prostředí, ale hrají také důležitou roli v komunikaci včel.
Celý článek je v tištěné a elektronické verzi Moderního včelaře.
Toto číslo Moderního včelaře si můžete zakoupit
Skrytá alchymie medu: Proč by včely měly produkovat medovinu, a ne med

Fabian Lindhe
206/4/20
Spolu s Mikem McInnesem, autorem knihy Honey Sapiens, se Fabien Lindhe věnuje některým méně známým objevům, vysvětlujícím překvapivý biochemický fakt, že med v úlu nefermentuje.
Celý článek je v tištěné a elektronické verzi Moderního včelaře.
Toto číslo Moderního včelaře si můžete zakoupit
Změna v jarním ošetření včelstev

- redakce
206/4/22
Státní veterinární správa v Praze uspořádala tiskovou konferenci k dozorové činnosti v roce 2025. Nákazová situace v chovu včel byla stabilní, avšak vzrostl výskyt hniloby včelího plodu.
Kde řádí asijská sršeň, není slyšet bzukot a cvrlikání

Lukáš Matela
206/4/23
V předvečer konference Člověk a včela 2025 jsem měl tu čest u piva vyslechnout postřehy přednášejících, které se nevešly do následujících. O ten, který se týkal sršně asijské, se nyní podělím.
Celý článek je v tištěné a elektronické verzi Moderního včelaře.
Toto číslo Moderního včelaře si můžete zakoupit